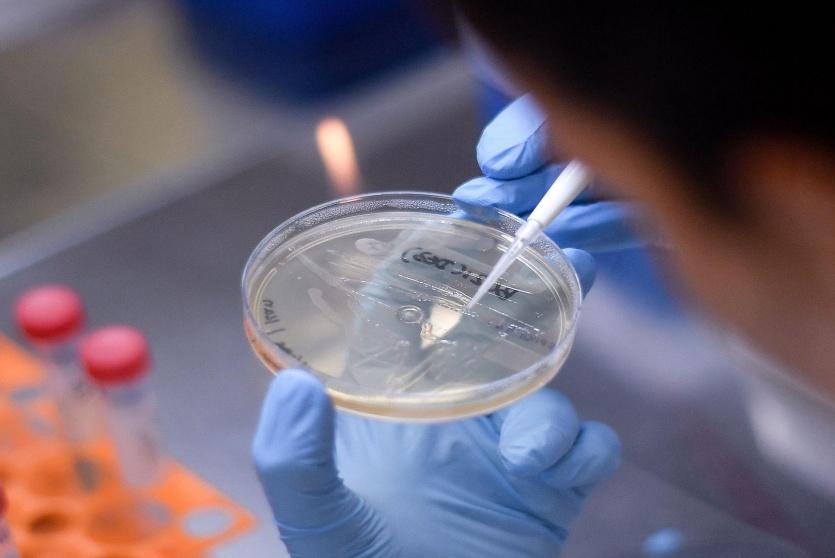
تجارب على لقاح

واقعة انتحار تعلق تجارب لقاح كورونا الصيني في البرازيل
تجارب على لقاح
علقت هيئة تنظيم الصحة في البرازيل التجارب السريرية على لقاح سينوفاك الصيني للوقاية من فيروس كورونا بسبب تطور بالغ الضرر، وهو ما يسعد الرئيس جايير بولسونارو الذي انتقد مرارا مصداقية هذا اللقاح وقال إن حكومته لن تشتريه.
وأوقفت الهيئة التجارب في ساعة متأخرة من مساء الاثنين، قائلة إن التطور حدث يوم 29 أكتوبر تشرين الأول.
وقالت حكومة ولاية ساو باولو، حيث تجري التجارب، إن وفاة أحد المتطوعين تم تسجيلها على أنها واقعة انتحار ويجري التحقيق فيها.
واجه اللقاح جدلا في البرازيل، إذ رفضه الرئيس بولسونارو باعتبار أنه يفتقر إلى المصداقية.
وتتناقض النكسة التي تعرضت لها جهود سينوفاك مع الأخبار السارة من شركة فايزر التي قالت إن لقاح كوفيد-19 التجريبي فعال بنسبة تزيد عن 90 في المئة بناء على نتائج التجارب الأولية.
المصدر: رويترز


